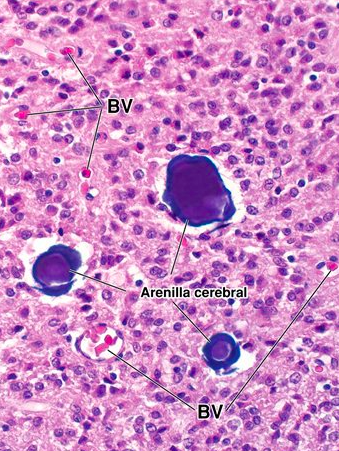

Hipotálamo: ¿en dónde se secreta OT y ADH?
OT=Supraóptico y
ADH= paravetricular
Células de la adenohipófisis y qué secretan:
- Somatótropas = GH
- Lactótropas = PRL
- Tirótropas = TSH
- Corticótropas = ACTH
- Gonadótropas = LH y FSH
Lóbulo posterior de la hipófisis =
Neurohipófisis
V/F neurohipófisis es una glándula endocrina:
Falso, es un sitio de almacenamiento para las secreciones
Productos que libera la neurohipófisis:
y funciones
- ADH = homeostasis hídrica
- OT = contracción músculo liso uterino y de conductos alveolares de la glándula mamaria (expulsión de leche)
Células de la glándula pineal:
- Pinealocitos
- Gliales
Distintivo de la glándula pineal:
Cuerpos arenáceos
Glándula endocrina bilobulada (lóbulos conectados por un istmo):
Glándula tiroides
Unidad estructural y funcional de la glándula tiroides:
Folículo Tiroideo
Células de la glándula tiroides y qué secretan:
- Foliculares = T3 y T4
- Parafoliculares = Calcitonina
¿De qué se compone el coloide?
Folículo tiroideo
Tiroglobulina, forma inactiva de almacenamiento de las hormonas tiroideas
Células de la glándula paratiroides:
- Principales = secretan PTH
- Células oxifilas = no se les reconoce función se cretora
Principales en H&E se ven más moradas
Suprarrenal
Capas:
Cápsula
* Glomerular
* Fascicular
* Reticular
* Médula
Suprarrenal
¿Qué secreta la zona glomerular?
Mineralocorticoides:
Aldosterona
¿Qué secreta la zona fascicular?
- Glucocorticoides: cortisol, corticoesterona
¿Qué secreta la zona reticular?
Gonadocorticoides = DHEA, androstenodiona
¿Qué secreta la médula?
Catecolaminas: Adrenalina y NE
Páncreas endócrino lo conforma:
Islotes de Langerhans
Células de los islotes de Langerhans y qué secretan:
- alfa= glucagon
- beta= insulina
- delta = somatostatina
- células P = polipeptidasa
¿Qué secreta la glándula pineal?
Melatonina
En la neurohipófisis en qué forma se almacenan los neurotransmisores:
Cuerpos de Herring


